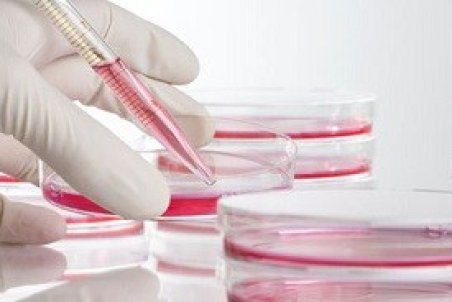
ذخیره خون بند ناف به چه درد می‌خورد؟

ورود
اطلاعات بالا را برای ثبت نام تکمیل کنید
ذخیره خون بند ناف به چه درد میخورد؟
مسئول بانک خون بند ناف جهاددانشگاهی خراسان جنوبی گفت: در تمام مراحل خونگیری تا ذخیره در بانک خون بندناف رویان تمامی شرایط استاندارد و مطابق با مقررات جهانی رعایت میشود.
1398/08/26 , 14:29
439
0
0